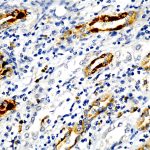
ANC37

|
|---|
 Anti-Alpha-Fetoprotein (AFP) Anti-Alpha-Fetoprotein (AFP)Buy here |
 Anti-Alpha-Tubulin Anti-Alpha-TubulinBuy here |
 Anti-AMACR Anti-AMACRBuy here |
 Anti-Anaplastic Lymphoma Kinase (ALK) Anti-Anaplastic Lymphoma Kinase (ALK)Buy here |
 Anti-Androgen Receptor Anti-Androgen ReceptorBuy here |
 Anti-Androgen Receptor Anti-Androgen ReceptorBuy here |
 Anti-Annexin A1 Anti-Annexin A1Buy here |
 Anti-Annexin A1 Anti-Annexin A1Buy here |
 Anti-Annexin VII Anti-Annexin VIIBuy here |
 Anti-Anti-IL-1a, Clone IL1A/3981 Anti-Anti-IL-1a, Clone IL1A/3981Buy here |